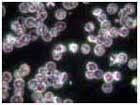
MRET Live Blood Cells Test 3 MRET Live Blood Cells Test 3

Patented Cell Phone Radiation Shield Technology was Put to the Test To See If It Can Neutralize the Harmful Effects of Electromagnetic Radiation from Cell Phones–
This simple biological experiment was conducted to verify the effectiveness of the cell phone radiation shield technology called MRET (Molecular Resonance Effect Technology). Samples of plant seeds, beans, and yeast microorganisms were placed in close proximity to cellular phones operating in stand by mode.
Here are the Results–
1st Day:
| Seeds exposed to EMR from mobile phone WITHOUT protection | Seeds exposed to EMR from mobile phone WITH MRET-Shield protection |

12th Day:

The above test results show that the installation of the proprietary patented MRET-shield technology on the mobile phone protects living cells of plant seeds against harmful, suppressive effects of electromagnetic radiation (EMR). (More details of this test here )
Here are a few more tests, this time on human subjects.
Notice how the MRET-shield technology is able to reverse the radiation
exposure effects in each case…
–
| Column 1 CONTROL – SUBJECT NOT EXPOSED TO CELL PHONE RADIATION – | Column 2 SUBJECT EXPOSED TO CELL PHONE RADIATION WITHOUT PROTECTION – | Column 3 SUBJECT EXPOSED TO RADIATION WITH MRET- SHIELD PROTECTION – |
Thermography Test:![]() Control | ![]() Temperature increase in areas of the face | ![]() Heat is reduced; compare w/ control |
Live Blood Cells Test:![]() Control | ![]() Pattern of Rouleau formation, lack of oxygen in red blood cells | ![]() Immediate restoration of blood cells formation |
EEG Brainwave Test:![]() Normal mode of brain function | ![]() Shows excitation of the brain function wave patterns | ![]() More coherent and optimized, close to normal |
(See details of above tests and more in our Research section.)
These tests (and more) clearly show this breakthrough proprietary patented MRET-Shield Technology will make your calls a lot safer–
Now, here’s the important part: MRET-Shield Technology is the main technology component of the GIA Cell Guard—
Quick Facts about the revolutionary GIA Cell Guard
![]() |
|
Don’t risk another phone call with a ‘microwave’ next to your head. The GIA Cell Guard is a scientifically validated mobile phone radiation protection solution you can confidently use against the harmful effects of cellular phone radiation–
Please don’t wait. Act now!

Click below and Watch Video to Learn More:

Click Here to See How it Works
Click Here to See More Test Results
*BIOPRO Technology products have been acquired by GIA Wellness. These are the same products with the renowned patented and proprietary technologies that are on the cutting edge of EMR intervention.
========================================
Frequently Asked Questions:
What are the health risks of mobile phone radiation exposure? What are their effects?
Numerous studies have been conducted over the years that have indicated a connection between the microwave frequencies emitted by the mobile phone and adverse biological effects. Even though these frequencies are nonionizing radiation and considered safe, research has shown reasons to be concerned. To learn more about the potential hazards of mobile phone use to your health, check out our article: Cell Phone Dangers: How Electromagnetic Radiation Disrupts Nature’s Design.
How can I be sure that your protection products really work?
The products we offer on this site have been independently tested and verified to reduce the negative effects of mobile phone radiation. For the MRET, for instance, which powers the GIA Cell Guard chip, you can check out our Research and Tests section.
What other radiation prevention measures do you offer or suggest?
Besides the Cell Guard, we also recommend the Air Tube Headset, which is a hands-free device like others you may be familiar with but with a difference: the GIA headset uses a patented air tube technology in place of a wire for transmitting the sound signals from your phone to your head. This prevents the microwaves from getting transmitted to your head! Learn more about in our GIA Air Tube Headset page.
Another popular choice is the PONG radiation-reducing case, which uses an innovative and patented technology to channel the radiation away from the head. Pong Research manufactures a wide-ranging lineup of radiation protection cases for various makes and models.
For expectant mothers, the Belly Armor blanket and clothing provide a much-needed safeguard for the delicate tissues of the unborn child. There have been studies that indicate the development of the unborn fetus can be adversely affected by exposure to these signals. Learn more about the Belly Armor products here.
Finally, there are ways you can do to limit your risks from using the mobile phone. We have compiled a short list about common precautions, and you can read them here: 10 Cell Phone Radiation Protection Tips.
The cell phone is a wonderful technology that has enabled a quantum leap in the way we communicate. We love our devices and use them just like everyone else does everday. However, because the ‘wireless’ environment it has engendered is relatively new, we need to be aware of potentially harmful consequences and take the necessary steps to protect our health.